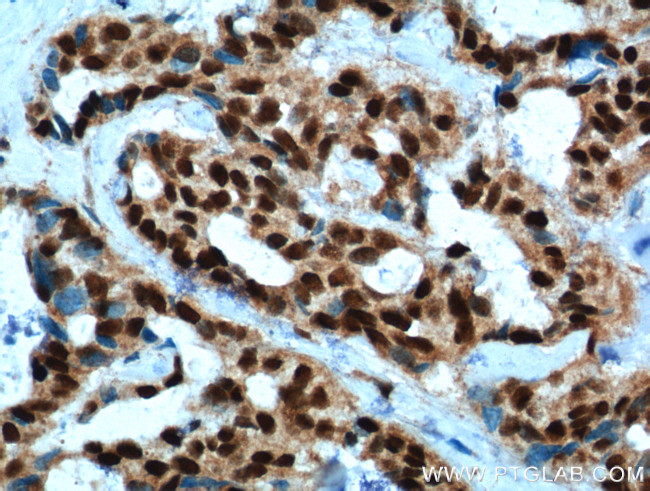
PYGO2 Antibody in Immunohistochemistry (Paraffin) (IHC (P))

Search
Proteintech
PYGO2 Polyclonal Antibody
{{$productOrderCtrl.translations['antibody.pdp.commerceCard.promotion.promotions']}}
{{$productOrderCtrl.translations['antibody.pdp.commerceCard.promotion.viewpromo']}}
{{$productOrderCtrl.translations['antibody.pdp.commerceCard.promotion.promocode']}}: {{promo.promoCode}} {{promo.promoTitle}} {{promo.promoDescription}}. {{$productOrderCtrl.translations['antibody.pdp.commerceCard.promotion.learnmore']}}
产品信息
11555-1-AP
种属反应
宿主/亚型
分类
类型
抗原
偶联物
形式
浓度
规格
纯化类型
保存液
内含物
保存条件
运输条件
产品详细信息
Immunogen sequence: FGGFRVQGG MAGQVPPGYS TGGGGGPQPL RRQPPPFPPN PMGPAFNMPP QGPGYPPPGN MNFPSQPFNQ PLGQNFSPPS GQMMPGPVGG FGPMISPTMG QPPRAELGPP SLSQRFAQPG APFGPSPLQR PGQGLPSLPP NTSPFPGPDP GFPGPGGEDG GKPLNPPAST AFPQEPHSGS PAAAVNGNQP SFPPNSSGRG GGTPDANSLA PPGKAGGGSG PQPPPGLVYP CGACRSEVND DQDAILCEAS CQKWFHRECT GMTESAYGLL TTEASAVWAC DLCLKTKEIQ SVYIREGMGQ LVAANDG (101-406 aa encoded by BC032099 )
靶标信息
The PYGO2 gene encodes pygopus family PHD finger 2, a key component of the Wnt signaling pathway, which is critical for embryonic development, cell proliferation, and differentiation. PYGO2 operates as a chromatin remodeling factor, interacting with the beta-catenin-LEF/TCF transcriptional complex, facilitating the transcription of Wnt target genes by recruiting chromatin-modifying enzymes. This activity is vital for maintaining the balance between stem cell renewal and differentiation in various tissues, including the brain and the skin. Additionally, PYGO2 plays significant roles in spermatogenesis and hematopoiesis by modulating gene expression necessary for these processes. Dysregulation of PYGO2 expression can lead to developmental abnormalities and is often implicated in cancer progression, indicating its potential as a biomarker for tumorigenic stem cell-like properties and metastatic behavior. Research continues to explore PYGO2's mechanisms and interactions to understand its contributions to development and its implications in disease states, particularly in cancer biology.
仅用于科研。不用于诊断过程。未经明确授权不得转售。
生物信息学
蛋白别名: mpygo2; nuclear; pygopus 2; Pygopus homolog 2; unnamed protein product
基因别名: 1190004M21Rik; PP7910; PYGO2; RGD1308535
UniProt ID: (Human) Q9BRQ0
Entrez Gene ID: (Human) 90780, (Rat) 295251, (Mouse) 68911